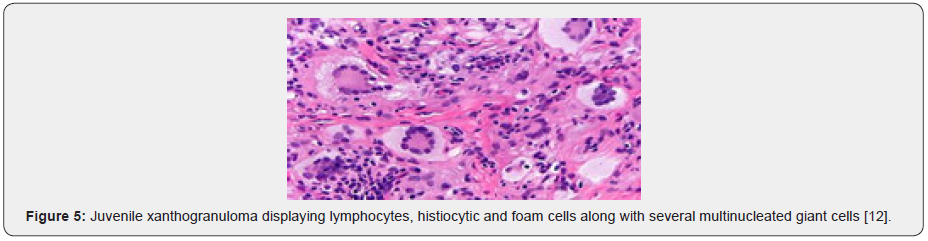
Click here to view Large Figure 5 Material Science

The Budding Scavenger-Juvenile Xanthogranuloma
Anubha Bajaj*
Consultant Histopathologist, Panjab University, India
Submission:February 24, 2021;Published:March 05, 2021
*Corresponding author: Anubha Bajaj, Consultant Histopathologist, Panjab University, India
How to cite this article: Anubha Bajaj. The Budding Scavenger-Juvenile Xanthogranuloma. Open Access J Surg. 2021; 12(5): 555846. DOI:10.19080/OAJS.2021.12.555846.
Abstract
Juvenile xanthogranuloma is an uncommon, proliferative, non-Langerhans histiocytic cell disorder arising from dendrocytes. Juvenile xanthogranuloma is commonly discerned in childhood and demonstrates a male predominance. Of obscure aetiology, juvenile xanthogranuloma appears as a consequence of a hitherto uncharted infectious or physical stimulus which engenders a granulomatous histiocytic response. Typically, juvenile xanthogranuloma represents as an asymptomatic, solitary or multiple, firm, yellow, orange or brown papule or nodule. Cutaneous lesions demonstrate an intense infiltration of histiocytic cells within the superficial dermis. Histiocytic cells are intermingled with mature lymphocytes, plasma cells and eosinophils. Also, foam cells, foreign body giant cells and Touton giant cells emerge within mature lesions. Immune reactivity to CD68, vimentin, alpha-1 antichymotrypsin, lysozyme, Factor XIIIa, macrophage inflammatory protein (Ki-MIP) and anti-CD4 is observed. Juvenile xanthogranuloma mandates a segregation from benign and malignant conditions such as Langerhans cell histiocytosis, reticulohistiocytoma, embryonal rhabdomyosarcoma, atheroma, dermatofibroma, xanthoma or lipoma, Conservative management is recommended, and surgical eradication of cutaneous lesion is curative in lesions situated in accessible sites.
Keywords: Juvenile xanthogranuloma; Renal parenchyma; Neurofibromatosis; Surgical eradication; Surgical excision.
Preface
Juvenile xanthogranuloma is an uncommon, proliferative, non-Langerhans histiocytic cell disorder arising from dendrocytes. The condition is additionally designated as nevoxanthoendothelioma. True incidence of juvenile xanthogranuloma may not be precisely ascertained as majority (90%) of lesions are miniature, solitary, papulonodular and remain undetected. However, cutaneous lesions of juvenile xanthogranuloma may be multiple. Self-limiting lesions of juvenile xanthogranuloma are usually devoid of complications. Juvenile xanthogranuloma is unrelated to metabolic or lipid disorders.
Disease Characteristics
Juvenile xanthogranuloma is commonly discerned in childhood. An estimated 75% instances appear within infancy at a median age of 5 months whereas in excess of >15% to 20% neonates demonstrate lesions at birth [1,2]. Juvenile xanthogranuloma is exceptionally discerned in adults between late twenties or thirties and may arise in the elderly population. Around 10% instances occur in adulthood and are designated as adult xanthogranuloma. Majority of incriminated adult subjects enunciate solitary lesions. Juvenile xanthogranuloma demonstrates a male predominance with a male to female proportion of 1.4:1 [1,2]. Of obscure aetiology, juvenile xanthogranuloma appears as a consequence of a hitherto uncharted infectious or physical stimulus which engenders a granulomatous histiocytic response. Lesions are commonly discerned within the face, trunk, neck, subcutaneous tissue and upper torso. Systemic, extra-cutaneous sites such as the ocular region, pulmonary parenchyma, hepatic parenchyma, renal parenchyma, testis, spleen, lymph nodes, bones, pericardium, central nervous system and gastrointestinal tract are exceptionally incriminated [1,2]. Oral lesions are infrequent, ulcerated, haemorrhagic and may appear as a yellowish nodule situated upon lateral tongue, gingiva, buccal mucosa and midline of hard palate. Additionally, oral mucosal lesions arise as verrucous, pedunculated, umbilicated or fibroma-like [1]. Juvenile xanthogranuloma of ocular region is unilateral and incriminates around <0.5% of subjects. Nevertheless, approximately 40% individuals with ocular juvenile xanthogranuloma demonstrate multiple cutaneous lesions at tumour discernment. Ocular involvement usually occurs preceding < 2 years. Ocular lesions require therapeutic intervention in order to circumvent possible complications such as blindness, glaucoma or hyphema [1,2]. Juvenile xanthogranuloma is associated with disorders such as juvenile chronic myelogenous leukaemia (JMML), urticaria pigmentosa, insulin-dependent diabetes mellitus, aquagenic pruritis, Niemann-Pick disease, neurofibromatosis and cytomegalovirus (CMV) infection [1,2]. Isolated intracranial lesions of juvenile xanthogranuloma are associated with a favourable outcome, in contrast to systemic disease. Aforesaid lesions delineate a BRAFV600E genomic mutation simulating Langerhans cell histiocytosis and Erdheim-Chester disease. Disease-induced morbidity is infrequent [1,2]. Multiple lesions of juvenile xanthogranuloma are observed in around 20% subjects, delineate a male predominance and are also associated with haematological disorders such as thrombocytosis, B-cell lymphoma, chronic lymphocytic leukaemia and monoclonal gammopathy [1,2].
Clinical Elucidation
Typically, juvenile xanthogranuloma represents as solitary or multiple, firm, yellow, orange or brown papule or nodule. Commonly, asymptomatic cutaneous lesions with a characteristic morphology are discerned wherein a majority of lesions undergo spontaneous involution within a year [3,4]. The asymptomatic, self-limited, painless, yellow-brown or yellow-red papules or nodules may enlarge up to 10 millimetres in dimension and engender plaques. Generally, juvenile xanthogranuloma appears as a solitary lesion situated upon the head and neck or upper trunk although no site of disease emergence is exempt. Cutaneous surface depicts numerous asymptomatic, yellow-brown, welldefined, soft to firm, pedunculated papules or nodular lesions of magnitude varying up to 15 millimetres. Subcutaneous lesions can be observed. Lesions are symmetrically disseminated upon upper or lower extremities, face, trunk or diverse incriminated sites [3,4]. Generally, juvenile xanthogranuloma demonstrates two distinct variants •a variant composed of multiple, domeshaped papules with pink to reddish brown to yellowish tingle and magnitude varying from 2 millimetres to 5 millimetres. A variant comprised of singular or multiple, enlarged nodules of magnitude one centimetre to 2 centimetres. Cutaneous lesions of juvenile xanthogranuloma are classified into three distinct categories as •miniature nodular or papular lesions of magnitude 2 millimetres to 5 millimetres •enlarged, nodular lesions of 5 millimetres to 20 millimetres •giant xanthogranuloma exceeding >20 millimetres in dimension. Adjunctive variants and clinical representations can be exemplified such as giant juvenile xanthogranuloma, atrophic plaque, cutaneous horn and subcutaneous mass. Systemic juvenile xanthogranuloma occurs in around 4% of incriminated children and displays an overall disease associated mortality of 5% to 10%. Systemic disease may be enunciated in neonates with consequent morbidity arising due to hepatic failure, giant cell hepatitis, progressive central nervous system disease and tumour infiltration within hepatic parenchyma and diverse viscera. Juvenile xanthogranuloma demonstrates ocular incrimination in nearly 0.3% to 10% of children implicated with cutaneous juvenile xanthogranuloma [3,4]. Majority of young children with ocular lesions are below < one year. Generally, ocular juvenile xanthogranuloma occurs within the iris or ciliary body and is associated with complications such as hyphema, spontaneous intraocular haemorrhage, ambylopia and glaucoma terminating in blindness. Spontaneous hyphema in combination with or absence of elevated intraocular pressure is frequently encountered in iris incriminated with juvenile xanthogranuloma [5,6]. Multiple lesions of juvenile xanthogranuloma characteristically exceeding > 5 lesions are uncommon wherein the lesions involute within 1 year to 5 years [4]. Associated central nervous system complications are seizures, elevated intracranial pressure, diabetes insipidus and delayed developmental milestones [4,5]. Extra-cutaneous lesions of juvenile xanthogranuloma are situated within deepseated soft tissues, spleen and pulmonary parenchyma. Common extra-cutaneous manifestation of juvenile xanthogranuloma are breast lump, non-traumatic iritis, hyphema and disturbance of gait [5,6].
Histological Elucidation

On gross examination, miniature, solitary or multi-centric, yellowish- red, papulonodular lesions of magnitude 1 millimetre to 2 centimetres are observed [5,6]. Well demarcated, cutaneous lesions demonstrate an intense infiltration of histiocytic cells confined to the superficial dermis which depict round, blunt rete ridges. Histiocytic cells are intermingled with mature lymphocytes, plasma cells and eosinophils. Mononuclear cells may be spindle-shaped or elongated. Foam cells, foreign body giant cells and Touton giant cells emerge within mature lesions. Multinucleated giant cells or Touton giant cells display a “garlandlike” configuration and are characteristically discerned in a majority (85%) of juvenile xanthogranulomas [5,6]. Ancient lesions depict an enhanced proportion of fibroblasts and replacement of inflammatory infiltration by fibrosis [6]. Typically, a cellular infiltration of histiocytes admixed with inflammatory cells as the lymphocytes, eosinophils, neutrophils and plasma cells is observed. Multinucleated Touton giant cells and lipidladen, foamy histiocytic cells are characteristic. Inflammatory exudate can extend to upper and lower dermis with frequent incrimination of subcutaneous tissue although lesions confined singularly to the epidermis are uncommon. Touton giant cells and histiocytes may be absent in preliminary lesions wherein the diagnosis is challenging [5,6]. Microscopically, upper and lower dermis demonstrates giant histiocytic cells or Touton giant cells admixed with foamy histiocytes and lymphocytic infiltration. Aforesaid infiltrate extends to the subcutaneous tissue. Superimposed epidermal layer is atrophic. An antecedent, poorly circumscribed, dense dermal proliferation of lymphoid and histiocytic cells is discerned along with an absence of giant cells. Gradually, foamy macrophages and Touton giant cells or associated multinucleated giant cells are delineated. Giant cells may be absent in extra-cutaneous lesions. Mature lymphocytes and eosinophils are admixed within the histiocytic cells. Abridged fascicles of spindle-shaped cells are followed by miniature fascicles of fibrohistiocytic cells and intermingled foci of fibrosis. The superimposed epidermal layer is attenuated with elongated rete ridges. Cutaneous adnexa are preserved. Dermal vascular configurations are prominent. The cellular component may display mild nuclear atypia although mitotic figures are absent. A variable, focal storiform pattern can be enunciated. Ocular lesions delineate an infiltration of histiocytic tumour cells with abundant cytoplasm. Infiltration of multinucleated Touton giant cells is decimated. On ultrastructural examination, tumour cells may demonstrate cytoplasmic lipid along with an absence of Birbeck granules [5,6]. (Figures 1-8).

Immune Histochemical Elucidation
Constituent cells of juvenile xanthogranuloma are immune reactive to CD68, vimentin, alpha-1 antichymotrypsin, lysozyme, Factor XIIIa, macrophage inflammatory protein (Ki-MIP) and anti- CD4. Tumour cells are immune non-reactive S100 protein and CD1a [2,3] .
Differential Diagnosis
Juvenile xanthogranuloma mandates a segregation from benign and malignant conditions contingent to clinical representation and site of tumour incrimination(2,4).
i. Langerhans cell histiocytosis is a condition with histiocytic cells demonstrating grooved, vesicular nuclei with a “coffee bean” appearance. Significant infiltration of eosinophils is observed. Langerhans cell histiocytosis is immune reactive to CD1a and S100 protein. On ultrastructural examination, Birbeck granules can be observed [2,4].
ii. Reticulohistiocytoma is a disorder arising from non- Langerhans histiocytic cells which histologically recapitulates juvenile xanthogranuloma. The lesion is composed of enlarged, mononuclear or multinuclear histiocytic cells admixed with a chronic inflammatory infiltrate of mature lymphocytes. Multinucleated histiocytic cells with a ground glass, eosinophilic cytoplasm are randomly distributed within the inflammatory exudate. Foci of dermal fibrosis are observed. Histiocytic cells are immune reactive to CD68 and immune non reactive to vimentin [2,4].
iii. Embryonal rhabdomyosarcoma delineates identical histological features with occurrence of monomorphic, miniature spherical cells configuring a superimposed “cambium” layer of malignant cells. Hypo-cellular and hyper-cellular areas admixed with loose, myxoid stroma are observed along with foci of tumour necrosis. Tumefaction is immune reactive to desmin, myogenin, vimentin and MyoD1. Differentiated cells are immune reactive to actin, myosin and myoglobulin [1,3].
iv. Atheroma denominates a flattened or elevated lesion composed of intracellular accumulation of lipids, a covering of endothelial cells and a fibrous cap comprised of smooth muscle cells, macrophages, lymphocytes, foam cells, connective tissue, cholesterol clefts and foreign body giant cells [1,3].
v. Dermatofibroma is a neoplasm demonstrating an admixture of fibroblastic, histiocytic, and myofibroblastic-like cells entangled within a dense collagenous stroma. Spindleshaped cells depict a scanty cytoplasm and thin, elongated nuclei. Focal storiform pattern is discerned. Superimposed epidermal layer depicts pseudo-epitheliomatous hyperplasia. The neoplasm is immune reactive to Factor XIIIa and immune non reactive to CD34 [1,3].
vi. Xanthoma is composed of uniform aggregates of foamy macrophages. The condition is associated with hyperlipidaemia [1,3].
vii. Lipoma is composed of mature, uniform adipose tissue cells imbued with lipid laden cytoplasmic vacuoles. The cellular aggregates are subdivided by fibrous tissue septa. Cellular and nuclear atypia is minimal and mitotic activity is absent. Necrosis of adipose tissue with infarct, calcification or histiocytic infiltration may be observed. Tumour cells are immune reactive to vimentin, S100 protein and CD34 [1,3]. Additionally, juvenile xanthogranuloma requires a distinction from entities such as diverse xanthomatous lesions, mastocytoma, dermatofibroma and Spitz nevus. Clinical segregation is mandated from conditions such as histiocytosis, neurofibromatosis, sarcoidosis and xanthoma [1,3].
Investigative Assay
Dermoscopy is a competent, non invasive technique adopted to adequately discern juvenile xanthogranuloma. On dermoscopy, a characteristic “setting sun” appearance with a definitive reddishyellow centric zone and discrete erythematous halo is observed. Comprehensive surgical eradication of the lesion with cogent tissue evaluation is diagnostic [7,8].
Therapeutic Options
Generally, conservative management is recommended for juvenile xanthogranuloma. Preliminary evaluation and therapy is mandated for circumventing complications of ocular juvenile xanthogranuloma [7,8]. Surgical eradication of cutaneous lesion is curative and is optimally recommended in lesions situated in accessible sites. Majority of lesions discerned in childhood involute and resolve spontaneously in the absence of pertinent therapy. However, localized tumour reoccurrence may be observed [7,8]. Non cutaneous or internal lesions may be challenging to treat and mandate employment of therapeutic combination of surgery, chemotherapy, radiotherapy and immunosuppression. Generally, chemotherapy and radiotherapy are optimal and employed for symptomatic, incompletely resected or extra-cutaneous disease unamenable to surgical excision. Ocular and systemic juvenile xanthogranuloma may retrogress with the adoption of radiotherapy, multi-agent chemotherapy or systemic steroids. Initiation of therapy on account of cosmetic concerns or appearance of systemic disease is engendered by surgical resection, degeneration with laser therapy, adoption of systemic agents as retinoids, isotretinoin, cyclosporine, oral corticosteroids, methotrexate, vinblastine and mercaptopurine. Following a pertinent ocular examination in incriminated subjects, topical, intra-lesional or subconjunctival corticosteroids may be administered for suitably treating ocular lesions. Complications such as glaucoma or hyphema can be treated with surgical eradication or systemic steroids. Prognostic outcomes of juvenile xanthogranuloma are superior as majority of lesions undergo spontaneous regression within 3 years to 6 years. Lesions incriminating vital organs or inducing cosmetic disfigurement can be subjected to adequate treatment. Routine ophthalmologic evaluation is recommended in order to exclude systemic involvement [7,8].
References
- Collie JS, Harper CD (2020) Juvenile xanthogranuloma. Stat Pearls Publishing, Treasure Island Florida, United States.
- Sadegh Vahabi-Amlashi, Masoumeh Hoseininezhad (2020) Juvenile xanthogranuloma- case report and literature review. Int Med Case Rep J 13: 65-69.
- Pantalon A, Ștefănache T (2020) Juvenile xanthogranuloma in an infant - spontaneous hyphema and secondary glaucoma. Rom J Ophthalmol 61(3): 229-236.
- Oliveira TE, Tarlé RG (2018) Dermoscopy in the diagnosis of juvenile xanthogranuloma. An Bras Dermatol 93(1): 138-140.
- Ferreira BR, Cardoso JC (2017) Multiple adult-onset xanthogranuloma, an uncommon diagnosis. An Bras Dermatol 92(2): 294-295.
- Meyer P, Graeff E (2018) Juvenile xanthogranuloma involving concurrent iris and skin: clinical, pathological and molecular pathological evaluations. Am J Ophthalmol Case Rep 9: 10-13.
- Mori H, Nakamichi Y (2018) Multiple Juvenile Xanthogranuloma of the eyelids. Ocul Oncol Pathol 4(2): 73-78.
- Haroche J, Abla O (2015) Uncommon histiocytic disorders: Rosai-Dorfman, juvenile xanthogranuloma and Erdheim-Chester disease. Haematology Am Soc Hematol Educ Program 571-578.
- Image 1 and 2 Courtesy: Dermnet NZ.
- Image 3 Courtesy: Webpathology.com.
- Image 4 Courtesy: Pathology Apps.
- Image 5 Courtesy: Libre Pathology.
- Image 6 Courtesy: Pathology outlines.
- Image 7 Courtesy: Research Gate.
- Image 8 Courtesy: Eyewiki.com.

















